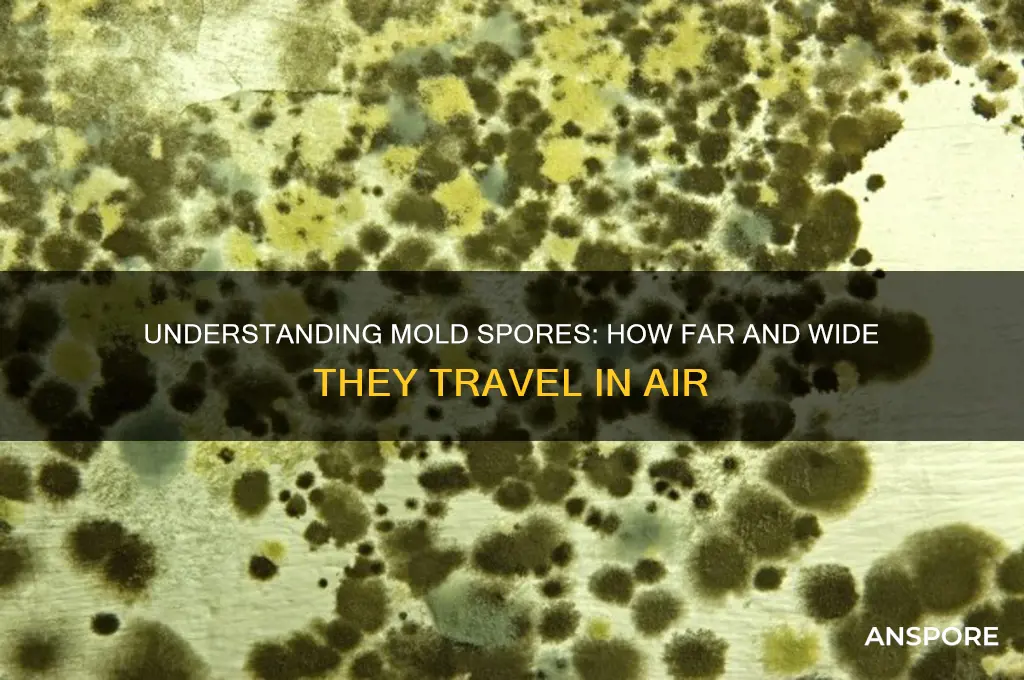
how airborne are mold spores

Mold spores are incredibly lightweight and easily become airborne, making them highly efficient at dispersing through the environment. These microscopic particles are naturally present in both indoor and outdoor air, but their concentration can increase significantly in damp or water-damaged areas. Once airborne, mold spores can travel long distances, settling on surfaces or remaining suspended in the air until they find a suitable environment to grow, such as a moist surface. Their small size allows them to infiltrate HVAC systems, clothing, and even human respiratory systems, posing potential health risks, especially for individuals with allergies, asthma, or compromised immune systems. Understanding the airborne nature of mold spores is crucial for effective prevention, detection, and remediation strategies.
| Characteristics | Values |
|---|---|
| Airborne Nature | Mold spores are naturally airborne and can travel through the air. |
| Size | Typically 2-20 microns in diameter, small enough to remain suspended. |
| Weight | Lightweight, allowing them to float and disperse easily. |
| Dispersal Mechanisms | Released during mold growth, disturbances (e.g., cleaning, wind). |
| Indoor Concentration | Higher in damp, humid environments with mold growth. |
| Outdoor Concentration | Naturally present in the air, especially in warm, humid climates. |
| Survival in Air | Can remain viable in the air for extended periods, depending on type. |
| Settling Time | Eventually settle on surfaces but can be re-suspended by disturbances. |
| Health Impact | Inhalation can cause allergies, respiratory issues, or infections. |
| Detection | Air sampling and spore traps are used to measure airborne levels. |
| Prevention | Reduce humidity, fix leaks, and clean mold to minimize airborne spores. |
Explore related products
What You'll Learn

Mold spore size and weight
Mold spores are remarkably small, typically ranging from 2 to 20 micrometers in size. To put this into perspective, a human hair averages about 75 micrometers in diameter, making these spores invisible to the naked eye. This minuscule size is a key factor in their ability to become airborne and travel long distances. When disturbed, whether by air currents, human activity, or even the simple act of walking on a carpet, mold spores can easily detach from their source and float through the air. Their lightweight nature, often weighing less than a trillionth of a gram, allows them to remain suspended for extended periods, increasing the likelihood of inhalation or settling on new surfaces.
The size and weight of mold spores also influence their behavior in different environments. Smaller spores, such as those from *Aspergillus* or *Penicillium*, can penetrate deeper into the respiratory system, potentially causing health issues like allergies or asthma. Larger spores, like those from *Cladosporium*, are more likely to be trapped in the upper respiratory tract or filtered out by the nose and mouth. Understanding these size differences is crucial for assessing health risks and implementing effective air filtration systems. HEPA filters, for instance, are designed to capture particles as small as 0.3 micrometers, making them highly effective at removing mold spores from indoor air.
From a practical standpoint, the size and weight of mold spores dictate how they should be managed in homes and workplaces. Because they are so lightweight, spores can be easily dispersed by fans, vacuums, or even opening windows, which may inadvertently spread mold contamination. To prevent this, use vacuums with HEPA filters and avoid disturbing moldy areas without proper containment measures. When cleaning mold, dampen surfaces to minimize spore release, and wear a mask rated to filter particles as small as 2.5 micrometers (e.g., N95 or higher). These precautions are especially important for individuals with respiratory sensitivities or compromised immune systems.
Comparatively, mold spores’ size and weight also make them resilient in various conditions. Unlike larger particles, they can remain airborne for hours or even days, traveling through HVAC systems or settling on surfaces far from their origin. This persistence highlights the importance of addressing moisture issues promptly, as mold growth can quickly lead to widespread spore dispersal. Regularly inspect areas prone to dampness, such as basements, bathrooms, and attics, and maintain indoor humidity below 60% to discourage mold proliferation. By understanding the unique properties of mold spores, you can take targeted steps to minimize their presence and protect indoor air quality.
Are Spores Legal in NC? Understanding the Current Laws and Regulations
You may want to see also

Airflow and spore dispersion
Mold spores are remarkably lightweight, measuring between 3 to 40 micrometers in size, which allows them to remain suspended in air for extended periods. This characteristic makes airflow a critical factor in their dispersion. Even the slightest disturbance, such as opening a window or walking through a room, can stir up spores from surfaces and carry them through the air. Understanding how airflow influences spore movement is essential for controlling indoor mold growth and minimizing health risks.
Consider the role of HVAC systems in spore dispersion. When air conditioning or heating systems are in operation, they create air currents that can transport mold spores from one area of a building to another. For instance, if mold is present in a damp basement, the spores can be drawn into the HVAC system and distributed to upper floors, even if those areas are dry. To mitigate this, regularly inspect and clean air ducts, replace filters every 1–3 months (more frequently in high-humidity environments), and ensure proper ventilation in moisture-prone areas like bathrooms and kitchens.
Airflow patterns also play a significant role in outdoor spore dispersion. Wind can carry mold spores over long distances, especially during dry and dusty conditions. For example, agricultural areas or regions with decaying vegetation may experience higher spore counts in the air. Indoors, strategic use of fans and open windows can help dilute spore concentrations, but caution is needed in humid climates, as this can introduce outdoor spores or exacerbate indoor moisture issues. A practical tip is to monitor local mold spore forecasts and limit ventilation during peak spore seasons, typically late summer to early fall.
The interaction between airflow and surface characteristics further complicates spore dispersion. Porous materials like drywall, carpet, and wood provide ideal surfaces for mold growth and spore release. When air moves across these surfaces, it can dislodge spores more easily than from smooth, non-porous materials. In remediation efforts, HEPA-filtered air scrubbers can be used to capture airborne spores during cleanup, reducing the risk of cross-contamination. Always wear N95 respirators and protective clothing when disturbing moldy materials to avoid inhaling spores.
Finally, the speed and direction of airflow directly impact spore concentration and travel distance. Faster air currents can carry spores farther and higher, increasing the likelihood of inhalation. For example, a ceiling fan running at high speed in a moldy room may spread spores throughout the space, while a slow-moving air purifier with a HEPA filter can help capture them. To optimize indoor air quality, position air purifiers in high-risk areas and ensure they are sized appropriately for the room—a CADR (Clean Air Delivery Rate) of at least 2/3 of the room’s square footage is recommended. By controlling airflow, you can significantly reduce the airborne presence of mold spores and protect occupants from potential health hazards.
Are Spores Haploid Multicellular Organisms? Unraveling the Mystery
You may want to see also

Humidity impact on airborne spores
Mold spores are remarkably resilient, capable of surviving in a variety of environments, but their ability to become airborne is significantly influenced by humidity levels. At relative humidity levels below 40%, mold spores tend to remain dormant and less likely to disperse into the air. However, as humidity rises above 60%, spores become more active and prone to suspension in the air, increasing the risk of inhalation and colonization in new areas. This critical threshold highlights the importance of maintaining indoor humidity within the 30-50% range to minimize spore dispersal.
Consider the mechanics of spore release: mold colonies produce spores as a reproductive strategy, and these lightweight particles are easily dislodged when conditions are favorable. High humidity softens the spore-bearing structures, such as hyphae and conidiophores, making spores more susceptible to air currents from everyday activities like walking, vacuuming, or even opening doors. For instance, in a bathroom with persistent 70% humidity, spores from *Aspergillus* or *Penicillium* species can become airborne with each flush of the toilet, due to the aerosol effect. Practical tip: Install exhaust fans in high-moisture areas and ensure they vent directly outside to reduce humidity-driven spore release.
From a health perspective, the impact of humidity on airborne spores is particularly concerning for individuals with allergies, asthma, or compromised immune systems. Studies show that indoor environments with humidity levels above 60% can harbor up to 300-500 mold spores per cubic meter of air, compared to fewer than 50 spores in drier conditions. Prolonged exposure to these elevated levels can exacerbate respiratory symptoms, with children and the elderly being the most vulnerable. To mitigate this, use dehumidifiers in basements, crawl spaces, and other damp areas, aiming to keep humidity below 50%. Regularly clean dehumidifier reservoirs to prevent them from becoming spore breeding grounds.
Comparatively, low-humidity environments are not entirely risk-free. While spores may remain dormant, they can still accumulate on surfaces and become airborne during disturbances like construction or cleaning. For example, in arid climates with indoor humidity below 30%, spores from *Stachybotrys* (black mold) can cling to drywall dust and become suspended when the area is disturbed. This underscores the need for a balanced approach: maintain humidity within the optimal range and use HEPA filters during activities that stir up dust. Monitoring humidity with a hygrometer and responding promptly to deviations can prevent both spore activation and accumulation.
In conclusion, humidity acts as a double-edged sword in the airborne dispersal of mold spores. While high humidity directly promotes spore release and suspension, low humidity allows spores to persist and await favorable conditions for dispersal. By understanding this dynamic, homeowners and building managers can implement targeted strategies—such as humidity control, ventilation improvements, and regular cleaning—to reduce airborne spore concentrations and protect indoor air quality.
Sunlight's Power: Can It Eliminate Ringworm Spores Effectively?
You may want to see also
Explore related products

Indoor vs. outdoor spore mobility
Mold spores are remarkably resilient, capable of traveling through the air over vast distances, but their mobility and behavior differ significantly between indoor and outdoor environments. Outdoors, spores are subject to natural forces like wind, rain, and sunlight, which can disperse or degrade them. For instance, wind can carry mold spores for miles, contributing to their widespread presence in the environment. However, outdoor spaces generally offer more ventilation, reducing spore concentration in any given area. In contrast, indoor environments often lack these natural dispersants, allowing spores to accumulate and thrive in confined spaces. This distinction is critical for understanding how mold spores become airborne and pose health risks.
In indoor settings, spore mobility is influenced by human activities and building conditions. Everyday actions like walking, vacuuming, or even opening windows can stir up spores, keeping them suspended in the air longer. HVAC systems, while designed to circulate air, can inadvertently spread spores throughout a building if not properly maintained. For example, a study found that indoor spore concentrations can be 10 to 100 times higher than outdoors in poorly ventilated homes. Practical steps to mitigate this include using HEPA filters, regularly cleaning air ducts, and maintaining humidity levels below 60% to discourage mold growth. These measures are particularly important for vulnerable populations, such as children, the elderly, and individuals with respiratory conditions.
Outdoor spore mobility, while less confined, is not without risks. Seasonal changes play a significant role, with spore counts peaking during warm, humid months. For instance, outdoor mold spore levels can exceed 50,000 spores per cubic meter during fall in some regions, compared to 1,000 spores indoors in a well-maintained home. While outdoor exposure is generally less concentrated, prolonged outdoor activities during high-spore periods can still lead to health issues like allergies or asthma exacerbations. Wearing masks during outdoor work or exercise in high-spore seasons can reduce inhalation risk, especially for sensitive individuals.
Comparatively, indoor spore mobility poses a more persistent threat due to prolonged exposure. Unlike outdoors, where spores are diluted by open air, indoor spores can remain airborne for hours, increasing the likelihood of inhalation. A single mold colony in a damp basement, for example, can release millions of spores daily, which then circulate through the home. This underscores the importance of early detection and remediation. Using mold test kits or hiring professionals to inspect for hidden mold can prevent long-term health issues. Additionally, sealing leaks, fixing water damage promptly, and ensuring proper insulation are proactive steps to limit spore mobility indoors.
Ultimately, understanding the dynamics of indoor vs. outdoor spore mobility empowers individuals to take targeted actions. Outdoors, awareness of seasonal trends and protective measures during high-spore periods can minimize exposure. Indoors, focusing on ventilation, humidity control, and regular maintenance can significantly reduce spore accumulation. By addressing these environments differently, one can effectively manage mold spore risks and create healthier living spaces. Whether through simple household practices or informed outdoor behavior, the key lies in recognizing the unique challenges each setting presents.
Can Most Bacteria Form Spores? Unveiling Microbial Survival Strategies
You may want to see also

Duration of spore suspension in air
Mold spores are remarkably lightweight, measuring between 3 to 100 microns in size, which allows them to remain suspended in air for extended periods. This buoyancy is a key factor in their dispersal and persistence indoors and outdoors. The duration of spore suspension depends on several variables, including spore size, air currents, humidity, and the presence of particulate matter. Smaller spores, such as those from *Aspergillus* or *Penicillium*, can stay airborne for hours or even days, while larger spores, like those from *Stachybotrys*, settle more quickly, often within minutes to hours. Understanding these dynamics is crucial for assessing mold exposure risks and implementing effective remediation strategies.
Air currents play a significant role in prolonging spore suspension. In indoor environments, HVAC systems, fans, or even human movement can keep spores aloft, increasing the likelihood of inhalation. For instance, a study found that mold spores in a room with active air circulation remained suspended for up to 48 hours, compared to 6 hours in a stagnant environment. To minimize airborne spores, reduce air turbulence by turning off fans during cleanup and using HEPA filters to capture suspended particles. Additionally, maintaining relative humidity below 60% can discourage spore release and settling, as mold thrives in moist conditions.
Comparatively, outdoor spores face more variables, such as wind speed, temperature, and precipitation, which influence their suspension time. Wind can carry spores over long distances, with some traveling hundreds of miles before settling. Rain, however, acts as a natural cleanser, causing spores to adhere to water droplets and fall to the ground. In urban areas, particulate matter from pollution can bind with spores, increasing their weight and reducing suspension time. This interplay of factors highlights the complexity of outdoor spore behavior and its implications for air quality and human health.
Practical steps can be taken to mitigate the duration of spore suspension indoors. First, identify and address moisture sources, such as leaks or condensation, to prevent mold growth at its root. Second, use air purifiers with HEPA filters to continuously capture airborne spores, especially in high-risk areas like basements or bathrooms. Third, during mold remediation, isolate the affected area with plastic sheeting and negative air pressure to prevent spore spread. For individuals with mold sensitivities or allergies, wearing N95 respirators during cleanup can reduce inhalation risks. These measures, combined with regular monitoring, can significantly decrease the time spores remain airborne and improve indoor air quality.
In conclusion, the duration of spore suspension in air is a critical aspect of mold management, influenced by spore size, environmental conditions, and human activities. By understanding these factors and implementing targeted strategies, it is possible to reduce airborne spore concentrations and protect health. Whether in homes, offices, or outdoor spaces, proactive measures can mitigate the risks associated with mold exposure, ensuring safer and healthier environments.
Unveiling the Truth: Do Mold Spores Initiate Growth?
You may want to see also
Frequently asked questions
Mold spores are extremely lightweight and can become airborne with minimal disturbance, such as air movement, vacuuming, or even walking through a contaminated area.
Airborne mold spores can travel significant distances, especially indoors where air circulation is limited. They can spread throughout a building via HVAC systems or open doors and windows.
Mold spores can remain airborne for extended periods, ranging from hours to days, depending on environmental conditions like humidity, temperature, and air movement.
Yes, inhaling airborne mold spores can trigger allergic reactions, respiratory issues, and other health problems, especially in individuals with asthma, allergies, or compromised immune systems.

























